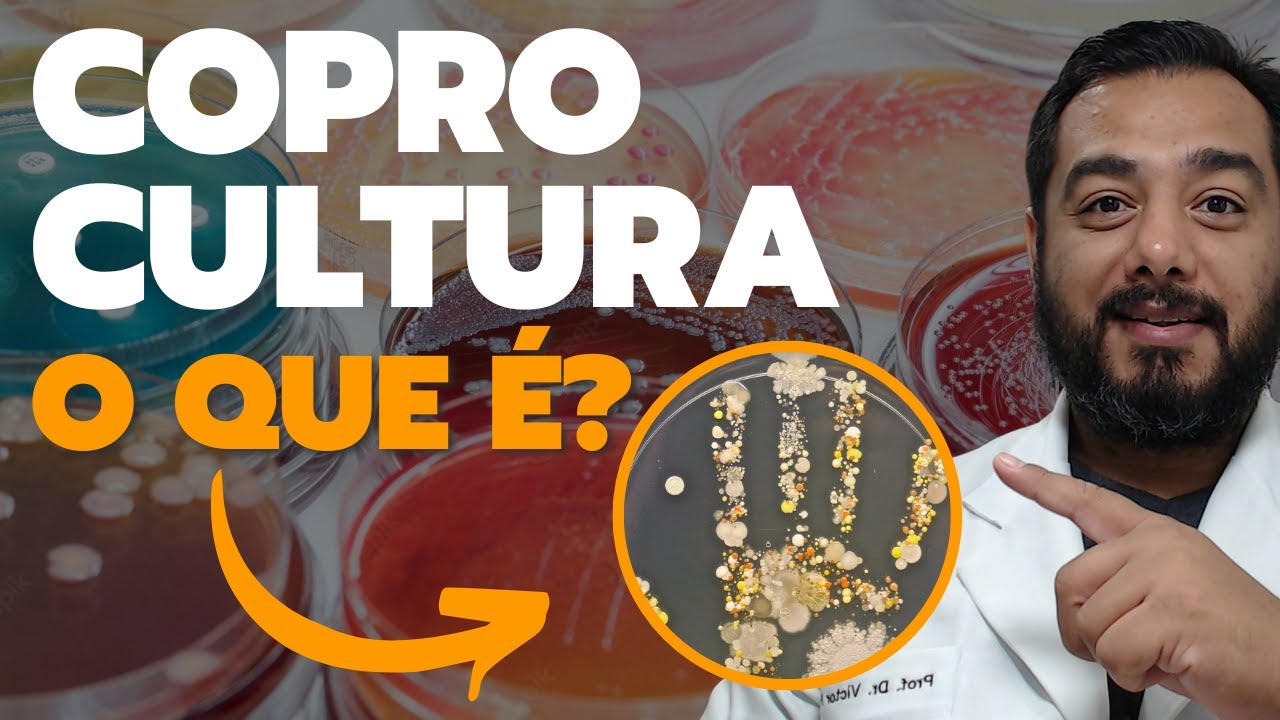

o Olá aqui é o professor Vítor Proença nesse vídeo a gente vai conversar um pouquinho sobre as principais vidrarias de laboratório tá então esse é um tipo de conteúdo aqui quem está fazendo para elaborar que esta trabalhar né questões de concurso público Principalmente para o cargo de biomédico bioquímico biólogo farmacêutico não é o farmacêutico bioquímico técnico de laboratório laboratório de análises clínicas alguma coisa nesse sentido ele pega várias questões e trabalha nesses conteúdos aqui são assuntos que caem normalmente concurso para biomédico principalmente na ebsl por exemplo vidraria lavagem de vidraria preparação de solução reagente e
etc Então hoje está trabalhando esse tipo de conteúdo se você gosta clica aqui em curtir e deixe o seu comentário e também se inscreve aqui no canal ativando todas as notificações para receber todos os próximos vídeos que tem coisa bacana vindo por aí tá então a gente vai pegar a várias questões também aqui mais para o meio da aula me explicar alternativa por alternativa mostrando para você a escolha Como que você pensa nesse sentido para resolver as questões a melhor forma Tá bom então vamos lá acho passar aqui no slide deixa diminuir só um pouquinho
essa essa tela para você enxergar bem aqui ó Isso aqui é um beck tá são Becker muita coisa que você já sabe é só revisão uma as você não pode arraste por questão Então a gente vai comentar aqui e trazer para você os principais as principais vidrarias de sim né materiais utilizados no laboratório não é tanta objetivo nessa aula trazer equipamento já gravar uma outra aula sobre isso e também na verdade não é objetivo aqui trazer sobre processos de esterilização tipo de água para laboratório e também vai gravar aulas específicas sobre isso hoje é mais
a comparação entre as vidrarias objetivos que que ele é utilizado e assim por diante né Então esse é um béquer tá essa maneira como pode ser escrita normalmente a gente escreve dessa maneira aqui mesmo né é para que que serve uso geral para de misturas etc com ou sem ocorrência de reação para misturar alguma coisa colocar uns um soluto solvente um sólido líquido e etc tá então dissolver sólidos em líquidos aquecer substâncias colocando por exemplo sobre uma tela de amianto Então você tem um tripé tem ali um bico de bom sem por exemplo ou ainda
um agitador magnético lá com aquecimento que você põe aqueles Peixinhos na ele gira e tal e aí você vai dissolvendo as substâncias que você quer ir tá bom ele é um material resistente porque é feito especificamente para isso tá E nesse caso especificamente você pode a que serve pode levar por exemplo para autoclave para esterilizar tá porque o béquer não é utilizado não é uma vidraria de precisão gente diz tá vidrarias de precisão é por exemplo pipeta volumétrica tá é o balão volumétrico que a gente vai citar ainda para você aí com bastante calma tá
e não é o ideal medir volume aqui no béquer se você quer alguma coisa mais precisa tá bom então pode comportar diversos volumes e não possui muita exatidão tá então dentro da escala assim de exatidão seria por exemplo volumes maiores balão volumétrico Veloso volumes menores app tá por exemplo volumétrico volumétrica e a esses que medem volume principalmente não devem ser aquecidos principalmente ir por exemplo para Autoclave já adiantando isso para você isso cai sim em questão de concurso público tá bom Aqui é um erlenmeyer você percebe que a boca é um pouco mais afunilada e
essa base aqui é um pouco maior ele consegue ser colocado por exemplo aqui numa tela de amianto sobre a bancada também para você preparar E aí é mais fácil você entornar assim virar por exemplo né então preparação de solução aquecimento de líquido armazenamento de solução por exemplo e uma boca mais estreita que é mais fácil e eu tenho Becker por exemplo que pode ser bem grandão assim né então no caso de animais você tem aquela boca um pouco menor que fica mais fácil de você virar por exemplo tá é mais fácil então o manuseio muito
utilizado em titulações que você coloca aqui me faz gotejamento né de soluções aqui por exemplo tá numa bureta menor chance de pedra de material então esses são alguns bairros dos benefícios de um Helen Mayer ele tem aqui algumas medidas você consegue perceber aqui nesse caso é de um litro tá mas não é uma vidraria de precisão também tá bom tubo de ensaio aí a utilização é meio que infinita né Mas normalmente testar reações e ações de microbiologia coleta de sangue materiais entre outros tipos você pode fazer para que serve substância em pequena escala aqui são
poucos ml se você tem um tubo reações colorimétricas E por aí vai muita coisa pode ser feita aqui em tubos de ensaio que pode ter turbo + bom né tamanhos maiores assim um volume um pouco maior e também todos bem menor está o só uma coisa Normalmente eles ficam nestas estantes aqui assim tá bom E aí você coloca os tubos em pé para eles para a reação processar para você enxergar né e tudo mais em que você precisa a gente tem os balões esse aqui é um balão de fundo chato que você pode apoiar na
bancada a gente também tem um outro balão que é fundo arredondado e é daqui a pouco eu expliquei com melhor mas assim a boca que o diâmetro da boca é menor o diâmetro aqui do bulbo ele é maior tá E nesse caso ele pode ser colocado sobre por exemplo uma tela de aumento para aquecimento então você pode fazer o que preparar soluções e soubesse substâncias por meio de agitação a que serve soluções e líquidos realizar reações em que há despreendimento por exemplo de gases porque você pode de repente encaixar aqui é um outro tipo de
vidraria e a vantagem de por exemplo pode ser colocado sobre a superfície e tem o risco de cair já o balão de fundo redondo não pode ser feito dessa maneira ele pode ser aquecida por exemplo sobre uma tela de amianto em um tripé com um bico de bom sem ali embaixo por exemplo E aí você pode com uma luva né específica de fazendo o quê agitando por exemplo ele coloca ali de novo a gente tá mais um pouco tira se for levantar fervura para usar em tudo de uma vez né que isso acontece em algumas
aulas por exemplo se preparar celular meio de Cultura alguma coisa do tipo isso pode acontecer Tá bom então é utilizado basicamente para isso não é para ficar medindo o volume aqui não é esse objetivo aqui nesse caso do balão de fundo chato né balão de fundo Redondo vantagem pode ser utilizado em uma manta aquecedora então Amanda fica ali em volta dessa base aí né que eles chamam de bulbo tá então fica ali e esquentando né grande parte daquele líquido que está ali e esse balão de fundo redondo e tirando um aparelho específico tipo um evaporador
rotativo alguma coisa nesse sentido e você encaixa aqui para para separação extração de óleos essenciais Seja lá o que for tá substâncias que têm pontos de fusão condensação sei lá o quê diferente né seria condensação diferente ponto de compensação diferente e aí você pega para sensual Qual é a água misturar álcool e água o álcool evapora né numa temperatura um pouco mais baixo você por exemplo pode utilizar depois de um condensador para fazer essa coleta ou ainda esquentar que plantas óleos essenciais etc os olhos vão ser arrastados por vapor e aí condensam lá você pode
depois fazer essa coleta e separação não funil de separação especificamente a gente vai falar também tá bom então para que que serve né aquecimento da solução por igual em todas as suas extensão líquido ficar girando aqui dentro por exemplo é uma possibilidade né muito utilizada em a destilação sistemas refluxo e evaporação a vácuo por exemplo acoplado a um rotaevaporador Essa é uma das coisas que eu citei por exemplo para extração de óleos essenciais Tá mas ele não consegue ficar em pé tudo bem ele tem que ficar acoplado né no aparelho especificamente que vai fazer esse
giro e numa manta aquecedora que envolve ele é bonitinho ele vai tombar obviamente né então diferente por exemplo do outro balão que é de fundo chato e a gente tem aqui ó balões volumétricos estar Essas são utilizadas para precisão medidas de volume de alta precisão então tem aqui por exemplo 100 250 500 ml Tá mas é uma medida única não dá para pegar nessa de 500 aqui por exemplo aí eu quero só 100 ml saque não dá não vai ter precisão porque tem aqui ó uma marcação certinha só para 500ml está Então você pega o
volume exato aqui bom então qualquer vantagem possui graduação volumétrica com maior precisão lembrando esse aqui que é de alta precisão você não pode esquentar por exemplo com água quente na Autoclave não pode esterilizar tá bom é o volume único e fixo descrito na parte externa do balão e são balão volumétrico tá tudo que tiver assim a palavra volumétrico você não pode esquentar porque pede para precisão Tá bom já adiantando para você aqui tem uma pipeta graduada você pode medir e transferir pequenos volumes de líquidos 20ml alguma coisa assim vantagem possui várias graduações ao longo do
seu tubo podendo medir volumes variáveis não que tem mais os risquinhos dá para perceber aqui que você consegue medir vários volumes tá essa não é uma pipeta volumétrica na pipeta volumétrica a gente já vai mostrar o volume também é o único assim como no balão volumétrico tá Então essa é uma desvantagem só que o volume é e olha aqui ó Isso é uma pipeta volumétrica Então essa essa daqui por exemplo é para você medir 10ml saque de 521 e assim por diante aqui tem um risquinho aqui ó então isso aqui é esse volume exato aí
é só isso tá que você tem que medir nessa pipeta volumétrica aqui então eu não consigo pegar na de 10 pegar 5ml por exemplo porque eu não tenho essa medida tá bom aí eu tenho que usar uma outra uma outra para 2 uma outra para um e assim por diante então vantagem precisão bem maior é um lembrando quando eu tenho aqui ó volumétrico é utilizado para mensuração mais precisa de volume todos os tipos de pipeta não podem ser aquecidos basicamente não Sugar com a boca então isso aqui também importante né usar a pera que a
gente disse que que você aperta o botãozinho puxa o link desse aperto o outro ou líquido saia setra aí alguma coisa assim que aparece questão de concurso público a se não for ácido você pode Sugar com a boca ou as se for sei lá o que não estiver quente você pode não não pode tá não pode ponto de maneira alguma qualquer coisa aí você não pode jogar com a boca porque pode ter contaminação Você pode ter uma infecção por exemplo então se tiver isso na afirmativa em alguns casos você pode Sugar com a boca não
não pode tá errado tá bom você tem que utilizar aparelhos ou alguma coisa específica como por exemplo a pera que a gente faz para puxar né basicamente o líquido até o volume específico que a gente quer aqui a gente tem uma aproveita aí Tem vários tipos também mas assim pode ser para mim de volume também tá mais agradar graduação volumétrica que é menos precisa já do que as pipetas por exemplo mas você pode medir volumes de líquidos e soluções líquidas transferir de um local para outro é mais fácil do que um béquer né mas para
você segurar por exemplo E aí tem um biquinho ali na conta para você virar e são várias graduações aqui que e você pode medir para 100 200 250 aqui nesse caso especificamente graduação volumétrica menos precisa que a da sua e pretas que a gente já citou aí tá bom bureta a boneca muito utilizada para titulação ela vem aqui ó uma torneirinha que você abra ele vai pingando você consegue controlar né gota-a-gota Por exemplo tá mas dá para colocar aqui em volumes específicos que você queira medir qualimed transfere volumes de líquidos o soluções possui uma torneira
em baixo aqui para escoar o líquido de forma rápida ou ainda gota a gota se houver necessidade de uma titulação muito utilizado então instalação para indicação de ácido e base tá então quando fala de titulação associa já com bureta tudo bem situação basicamente vou medir PH né verificar exatamente o valor de PH que muda a coloração desse meio aí com um indicador e é isso é um funil então o funil na verdade é o usado na verdade ao contrário né dessa imagem aqui que tá mostrando você pode colocar um papel filtro aqui para ele filtrar
alguma coisa ou ainda transferir de um pack para uma proveta que é Menorzinha ali para você nos correr nada não cair fora você coloca o fone lá em cima aí passa do béquer para prover o tubo de ensaio ou seja lá o que fora né então realizar infiltrações simples com auxílio de um filtro de papel e você dobra e coloca aqui ó filtro de papel eh transferência soluções sem perdas de material também é interessante Então isso é um funil funil analítico né mas não foi basicamente tá esse é um outro tipo de funil que é
um funil de separação tá me chamado disponível de bromo é aqui basicamente a gente se separa líquidos que são vai imiscíveis né ou soluções heterogêneas por exemplo mas Apolar e aqui embaixo mais polar por exemplo que têm densidades né bom então fazer para o óleo água vamos falar dessa maneira tá você é quando for fazer essa separação O que é mais por exemplo aquoso que tem uma polaridade aqui que é mais polar que a gente disse você vai tirando aqui por baixo e aí o que sobrou Depois você tira aqui por cima que é Apolar
é um realiza a separação de misturas heterogêneas do tipo líquido líquido por diferença de densidade essa definição aqui as aparece nas questões de concurso público tá é o que que é funil de separação ou também chamado de funil de bromo possui uma torneira na parte de baixo para escoar o líquido que ela é mais denso o líquido menos denso é retirado pela parte superior depois que já passou tudo bonitinho e você fez essa separação aqui então olha esse é feito dessa maneira por exemplo é muito solo né não todos mas muitos olhos são extraídos dessa
maneira com um balão de fundo Redondo uma manta aquecedora um evaporador rotativo um condensado Oi e aí o óleo é arrastado junto com a água que você esquentou lá naquela planta Flor Ou seja lá o que for né ou se arrasta ele condensa depois com aquela água que tá mais fria e aí pinga vem para cá e isso é para aqui ó o óleo essencial e aqui a água que eu acho que é hidrolato até que chamar se eu não me engano E aí fica com cheiro bem interessante isso daqui você pode utilizar para diversas
funções a específicas né Então esse é um funil de separação ou funil de bromo aqui a gente tem um extrator de soxhlet que é para extração de sólido sólido fica aqui ó bem nesse local aqui ó extração de lipídios por exemplo de materiais no estado sólido aqui você tem um aquecimento do solvente somente vem para aqui ó nesse sentido condensa aqui né que a gente tem uma entrada de água para resfriar esse aqui é um condensador condensa esse vapor que vem aqui ele pinga bem aqui e faz a extração desse componente que tá aqui ó
tá então é para extração e de sólidos Neve materiais do estado sólido permite a operação sem necessidade de monitorização constante por quê que levar para condensa pinga aqui evapora condensa e Pinga aqui e aí aqui tá crescendo né basicamente tem uma manta aquecedora esquenta evapora condensa e Pinga aqui de novo fazendo essa extração na hora que enche ele cria essa diferença aqui depressão né E aí pinga aqui de volta você fazendo extração do lipídio por exemplo que tem aqui nesse nessa estrutura aqui tá usar pequena quantidade de solvente porque você reutilize esse somente a isso
é bastante interessante e dissolve grande quantidade desse composto específico que você quer então esse é um extrator de soxhlet tá Aparece sim questões de concurso público apesar de ser utilizado em áreas né específicas aí de pesquisa não é em todo o laboratório que tem um desse não aqui é um bastão de vidro bem simples na verdade bastão é isso daqui ó que tá na sua mão seria a mão direita do pesquisador aqui a misturar mexer agitar ou seja lá o que for mas será né Um pouquinho aí o que você tem não é tão específico
para maceração Mas é para misturar ajudar a misturar em alguns casos a gente também pode colocar ele o bastão de vidro e isso correr por exemplo uma substância para entrar numa boca que é mais fininha que é mais afunilado da por exemplo mas você pode utilizar também um funil de vidro e funil analítico que a gente já disse aí para você também tá bom isso é um condensador então pode ser utilizado um vários aparelhos mas basicamente você coloca aqui uma água é fria né que ela fica aqui passando por aqui e ela condensar o vapor
da água do produto que você tá fazendo a condensação é tão condensará o like e fazer vapores muito utilizado em destilação para separar misturas homogêneas do tipo sólido-líquido líquido-líquido que a gente já citou aí por exemplo acoplado no evaporador rotativo por exemplo né então condensadores MA o caso mais comuns são de libby e são retos de bolas e também o de serpentina aqui ó bem bonitinho dá para enxergar bem certinho está aqui tá na imagem anterior nesse aqui também tem mas é o mais o de bola né isso também é um condensador que a água
entra esfria e isso que tá o vapor aqui o vapor condensa e cai de novo aqui tá bom nesse caso ela me ideia né aqui você entra na água fria sai água quente aqui e tal e passa uma água bem gelada por exemplo né que entra aqui e o vapor tá aqui dentro dessa serpentina obra em bonitinho aqui dentro e ele vai Basicamente já aconteceu o que vai virar líquido de novo e vai condensar pingar no outro funil de separação alguma coisa do tipo tá bom Aqui são placas de Petri muito utilizadas por exemplo na
microbiologia tá aqui são placas para dois meios por exemplo né com medidas aqui para vou tentar fazer uma contagem de bactérias mas não é só amigo tá bom que é utilizada mais muitas vezes a gente usa para fazer o quê meio de Cultura bacteriológico para fungo tá mas você pode utilizar também para germinação de plantas grão de pólen para avaliar comportamento de pequenos animais tá reações em escala reduzida deixar repousar que estais infiltrados tem outras funções aí para gente tem que dar a biomédica é muito comum placa de Petri seja de plástico ou também de
vidro né vidro você pode colocar no na esterilização né Por Autoclave por exemplo vapor úmido ou seco né calor sei que a gente disse que era uma estufa agora de plástico você descarta depois de realizar a esterilização na Autoclave mesmo tá aqui é o vidro de relógio você pode colocar por exemplo um poque alguma coisa do tipo para você analisar é pesar alguma substância inclusive o vidro a ser utilizado para tampar a boca de outros tipos de vidrarias aí né só pesar pequenas quantidades de substâncias evaporar soluções cobriram Becker por exemplo outro recipiente para não
deixar o líquido o a solução evaporar ou ser contaminada e ele não pode ser aquecido de diretamente esse tipo de vidro de relógio aqui tá é por mais estranho que possa parecer fácil Nossa mas é uma coisa simples assim né mas cai em questão de concurso público tá bom e E aí muitas vezes eu não lembro o nome você utiliza mas às vezes me lembro o nome você pega lá na perta o negocinho lá para a gente colocar o pozinho e medir né e pesar mas ele se chama vidro de relógio tá bom Oi aqui
é um de secador é um recipiente que você passa por exemplo aqui vaselina ou silicone por exemplo né graxa de silicone aqui na tampa e no encontro da tampa com a base ali para evitar trocas gasosas e etc ele fica hermeticamente fechado é um recipiente fechado e contém um agente de secagem que é um dessecante geralmente sílica gel que fica aqui embaixo por exemplo tá seus produtos vão ficar aqui em cima é que vem uma tampa é que vai por exemplo você tirar o ar de dentro né Tira aquela forma pressão E aí ele segura
ele ficar bem forte segurando a tampa possui uma lubrificação com graxa de silicone que fecha hermeticamente aqui para você não umidificar esse meio aqui interno que você tem tá bom tem usado para guardar substâncias em ambientes com baixa o teor de umidade você tirou a aqui acaba tirando o vapor da água que já está presente aqui também e aí conserva melhor a substância que você precisa aí mas o medicamento algum reagente alguma coisa do tipo tá aqui é um kitassato Ele parece um Hellen Mayara mas tem um aqui ó uma entrada para você colocar pressão
aqui por exemplo né é um possui uma ou mais saídas laterais onde a cópula se o sistema de pressão para sucção do filtrado muito utilizado por exemplo em filtrações a vácuo então parece o Neymar ele mas ele tem aqui a uma ou duas entradas ou saídas na verdade né para fazer alta pressão aí tá bom Aqui é um funil de buchner Ele é todo furadinho assim diferente do Funil que a gente já disse que é uma analítico que tem uma única saída lá então para fazer filtração que é feito em porcelana possui orifícios no seu
interior e é utilizado juntamente com o kitassato para realizar filtrações a vácuo também você pode substância aqui e coloca no vácuo ele vai trazendo alta pressão para fazer essa filtração aqui você quer uma pisseta bem simples na verdade você coloca você lá agora Como por exemplo o cloreto de sódio pode colocar hipoclorito de sorte armas todas identificadas obviamente né Cada um com seu objetivo aí para locar por exemplo soluções e reagentes como água destilada deionizada detergente e etc tá possui um bico aplicador para transferir o líquido você aperta o líquido vai isso aí não precisa
vir ao que realmente se você virar e não vai sair nada porque ele faz a sucção aqui por baixo Então aqui tem um líquido ele suga vem por aqui e sai aqui nessa nesse biquinho aí mas dosador né de quem mais fino na verdade tá aqui é um almofariz que as estrutura aqui mais externa e isso aqui é um pistilo basicamente para esmagar alguma coisa aí né então é um material cerâmico ou em vidro utilizada para trituração e maceração de sólidos em pequena escala e ele diminui o tamanho das partículas facilitando depois da solução no
meio aquoso tá Oi Magali a massa o que você tiver necessidade parece meio que um Pilão né que a gente Às vezes tem na cozinha parecido com isso mesmo tá porque aqui é mais específico tá o material que não fica com cheiro tipo aqueles de madeira assim que não é muito legal né pode ter contaminação então isso aqui é um cadinho tá é isso aqui Pode Ser esquentado é uma pequena recipiente de forma que se assemelha é muito um pote usado no aquecimento de sólidos a temperatura elevadas aqui você esquenta muito esse tipo de substância
que fica aqui dentro é de cerâmica também e você esquenta para verificar a saída de vapor de água a umidade né entre outras coisas tá isso aqui também é uma cápsula de porcelana normalmente usada para evaporação de líquido ou em Areia aquecida Chapa ou ainda bico de bons em alguns casos também em busca que é um forma com a temperatura aí em torno de seiscentos graus aproximadamente estão aqui é mais para aquecimento de e a cápsula de porcelana e o Cadinho mais para aquecimento de sólidos também alta temperatura tá bom Beleza então são os principais
são os principais vidrarias utilizadas no laboratório digital e se encontra em um abraço tório que você trabalhou já alguma outra coisa do tipo mas também são as principais das questões pode ficar tranquilo porque essa nosso objetivo aqui vamos lá então para as questões tá questão de 2014 Federal da Bahia para biomédico Qual das vidrarias apresentadas oferece maior precisão e exatidão vou circular está aqui ó precisão e exatidão quando é necessário preparar volumes o pai eu quero alguma coisa volumétrica outra coisa de grandes volumes tudo bem é um grande volume se eu tivesse uma pipeta aí
ó eu já ia excluir tudo bem Então olha que legal aqui ó e aqui a gente tem um kitassato representado não é para isso aqui é um béquer não é para isso que tem alta precisar um tá aqui é uma lei Mar Não é para isso aqui é uma proveta necessariamente não é grande volume então excluo essa daqui também para a gente sobrou o balão volumétrico número três é Nossa alternativa correta tudo bem E sem não falasse por exemplo ó volumes grandes falar se preparar volume de seus atos mais precisos né e tivesse uma pipeta
volumétrica e não teria a resposta correta tá bom parece caso é um balão volumétrico beleza questão 2014 também para biomédico Considerando o preparo de uma solução com o volume final de 1 litro Qual das vidrarias é mais adequada para se obter esse volume com maior precisão um volume de 1 litro eu não consigo numa pepeta por exemplo tá então já esquecem hein e a pequena nesse caso que tem ó maior precisão eu vou circular isso daqui Porque para mim é importante eu vou circular isso aqui tá Mel 1 litro 1 litro é mais volume Tudo
bem então eu uso nesse caso um balão volumétrico tá Só para constar né o béquer não tem alta precisão aproveita normalmente é sem MS né são volumes menores o Helen Mayer também não é para dissolver solução e etc condensado não condensador não tem nada a ver com isso daqui tá é para o vapor da água evaporar lá e quando as sabe porque tá uma temperatura menor a gente sobrou o balão volumétrico como já passou aí o slide Você já viu a resposta aí né Mas é isso mesmo se já tinha pensado tá bom questão 2014
ao ACP para biomédico também tá vou deixar aqui mas para baixo para a gente poder se enxergar melhor aí e trocar mais ideia aqui né das vidrarias mencionadas a seguir assinale a alternativa com a vidraria que e não mede nem transporta volume nem transporta volumes Então vamos lá não é para mim de volume Não é para transportar volume Esse é o ponto principal bureta pode ser utilizada para medir volume até pode né para transportar até pode então é isso aqui não é pipeta mid-volume eu posso Opa almofariz essa resposta Já correta logo de cara aqui
tá aproveita eu posso utilizar aqui também então não é a resposta que eu quero balão volumétrico também não tudo bem letras e é a nossa alternativa correta nessa questão que não mede o volume Não utilizada nesse sentido beleza estão 4/2003 da ebserh para biomédico Então isso é muito comum na época tá esse tipo de conteúdo aqui e aí a é para você comer um grande concurso e tem várias cidades assim né várias regiões a gente acaba tendo outras concursos de cidades menores que o meu do programático dessa prova Tá bom então se você se basear
aqui no concurso da ebserh Você estuda para muito concurso para biomédico vamos lá assinale a alternativa que indique somente vidraria só somente tá círculo isso aqui tem uma palavra importante também tá vidrarias utilizadas em laboratório com precisão volumétrica olha aqui palavra-chave importante ó precisão volumétrica balão volumétrico pipeta volumétrica são os dois principais aqui para a gente tá então vidro de relógio cara precisão não tem nada a ver com esse bureta também não mas tudo bem Becker e balão volumétrico é mais ou menos aqui a gente poderia ficar em dúvida né precisão volumétrica bem aqui bom
mas tudo bem é balão de fundo chato fundo redondo e pipeta graduada essa aqui não é tá proveta graduada e pipeta volumétrica pipeta e é tudo bem então você poderia ficar em dúvida entre a b&a de aqui nesse caso aqui está dentro da graduação aí né que tá mais próxima aí da pipeta é Aproveita tudo bem mas se você poderia ficar em dúvida aqui por exemplo o balão volumétrico eo bakero né É é porque o Uber também é utilizado para medir volume mais não é com precisão volumétrica nos primeiros acho que primeiros lado aqui dessa
aula praticamente a gente já falou aí que o Beca não era tudo bem mas dá para ficar em dúvida nessa questão letra de é a alternativa correta tá bom questão 5 a hora CP 2018 analista em saúde biomédico da Secretaria Estadual de Saúde de Pernambuco para a preparação de uma solução no laboratório de análises clínicas o técnico de laboratório eu precisava de um recipiente muito preciso que aguenta circula aqui tá bom devido à necessidade de a pressão de volume exato também círculo está aqui estando com dúvida sobre qual vidraria usar solicitou ajuda ao biomédico indicou
indicou Qual dos recipientes seguintes recipientes como o mais preciso mas precisam ir na história pra volume um pouco maior e geralmente é balão volumétrico mas vamos ver vamos ver se é isso mesmo né um béquer de 2000ml Então não é o mais preciso balão volumétrico Opa é Talvez seja essa vou lá continuar Becker também não profeta também não Becker também não tá então ele precisa mentir um volume e pediu ajuda para o biomédico o mais preciso é um balão volumétrico de 100 ml Claro que vai depender do volume querer precisar se ele precisa de um
litro é melhor usar um balão volumétrico de um litro né e assim por diante mas nesse caso é o balão volumétrico tá é um balão volumétrico volumes maiores pipeta volumétrica volumes novamente um pouco menores proveta na sequência tá E aí entra nem os outros que não são tão precisos O que são seis 2019 São João da Boa Vista técnico de laboratório em análises clínicas Considere a margem a seguir você quer um soxlet de cara aqui tá extrator de soxhlet Então não é uma pe-160 aquele negócio que você aperta lá para sair a água então né
para colocar para se por álcool etc trompa de vácuo não tem nada a ver não é agitador magnético um grande a ver então é um extrator de soxhlet como a gente já tinha mostrado para você tá bom Aqui também São João da Boa Vista técnico análises clínicas Considere a imagem a seguir a vidraria apresenta apresentada acima denomina-se isso é um Helen Maia tá sempre procura se tem uma coisinha assim uma uma uma saidinha ali de ar né que você pode colocar pressão para evaporação Não é esse o caso não tem não ele poderia são kitassato
Tá mas não tem então vamos lá letras e é um Helen Mayer olha aqui ó que eles querem confundir tá bom a classe alternativa correta é São João da Boa Vista também técnico laboratório análises clínicas para separação de líquidos imiscíveis Qual das vidrarias a seguir é indicada funil de buchner pipeta graduada kitassato ou funil de decantação é folha de busca não tem nada a ver né para filtração pipeta também não tem nada a ver é para medir volume que tá Saci também tem a ver com pressão etc só sobrou para gente aqui ó o funil
de decantação tá bom para separação de líquidos imiscíveis E aí a gente tem várias imagens aqui ó na questão de numero 9 de 2018 da ebserh para técnico em citopatologia Olha isso aqui é uma Autoclave balão volumétrico placa de Petri aqui é utilizado na praça para fatiar na verdade né para fazer lâminas aqui são pipetas aqui é um peagametro tá a figura considerando os equipamentos e as vidrarias indicados na figura nas figuras precedentes julgue o item o seguinte tem a figura 3 ilustra placas de Petri um dois três placas de Petri amplamente utilizadas em pesquisas
microbiológicas na obtenção de colônias bacterianas puras por meio da técnica de esgotamento por estrias precisa saber que é uma porca de pedra tá basicamente é isso alternativa aqui está correta tá é a mesma questão é e continuando né a vidraria ilustrada na figura 2 é uma bureta figura 2 é um balão volumétrico da logo de cara não é uma bureta indicado para correta dosagem volumétrica de reagentes empregados em titulações não tá errado isso aqui tá bom é um balão volumétrico questão 11 Deixa eu voltar aqui pro canto para a gente se enxergar adequadamente aí Pedro
da Paraíba 2016 técnico em laboratório análises clínicas a peça de laboratório cuja função é aquecer substâncias a seco e com grande intensidade podemos ser levado ao bico de bom sem é cadinho cadinho pode né olha que ser substâncias aí a seco e com grande intensidade Mas tudo bem vamos lá indo lá kitassato que dá saco não de secador também não é para evitar a umidade né A e por exemplo fazer filtração com alta pressão etc o evaporador rotativo cápsula de porcelana seria mais para líquido que fala substâncias a seco isso aqui também ó pode confundir
numa questão tá você não prestou atenção aquecer substância na sua cabeça ficou lá cápsula de porcelana aí você não prestou atenção não circulou que a seco tá a seco é Cadinho cápsula de porcelana nesse caso vai tá errado tá então a alternativa correta para gente nesse caso especificamente é a letra A Cadinho tudo bem é isso aí gostou desse conteúdo clique aqui curtir deixe o seu comentário se inscreve aqui no canal de barco cursos ativando todas as notificações tá eu sei que esse conteúdo é mais revisão mas ele cai nas provas então assista essa aula
antes de um concurso público em uma melhoria rapidinho acelera e a aula Se você quiser e vai treinando e faz questões também concurso público ela tem mais dezenas de questões lá no o tempo para você treinar beleza só para fechar o vídeo eu te convido a conhecer o passaporte babyflix a nossa plataforma de cursos dentro da área da saúde lá você tem mais de 50 cursos certificados já o certificado já incluso não paga nada mais por isso você tem acesso a todos esses cursos cursos por um ano com uma única assinatura tá essa todas as
materiais já pode caso você baixa salva em PDF imprimir apresenta na faculdade na pós-graduação processo seletivo concurso público para a Progressão de carreira ou seja o que for mais importantes na sua carreira nesse momento né coloca lá no Linkedin e para você mostrar que você fez um curso novo e também tem outras coisas importantes dentro do passaporte Barclays tá treinamento de carreira elaboração de currículo é preparação para entrevista de emprego elaboração de perfil do LinkedIn é um tudo isso eu tenho certeza que vai ajudar muito na sua carreira mas somente se você tá na faculdade
se formou agora se formou recente por exemplo ou tá afastado da faculdade que em alguns conceitos para prestar uma prova por exemplo da Karen isso tudo em tem recursos daqui são em vídeo aulas materiais complementares algumas questões aí de concurso público para você treinar seus conhecimentos tá e tem muita coisa bacana Além disso tudo você tem o meu suporte e o suporte também equipe para tirar todas as dúvidas que você tiver sobre os diferentes assuntos dentro da área biomédica tá bom é isso aí Obrigado por você me ouvir até agora meu nome é Victor presença
um grande abraço e até a próxima aula